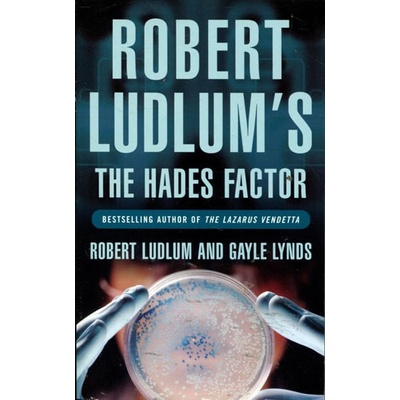

Knihy Robert Ludlum
 Robert Ludlums The Moscow Vector Ludlum Robert
Robert Ludlums The Moscow Vector Ludlum RobertRobert Ludlums The Moscow Vector Ludlum Robert
- Robert Ludlum
- anglické
- 544
- 2010
A once-great nation is determined to rebuild its shattered empire and lightning military strikes against its neighbours are planned. But first they must sow confusion and fear...
 Holcroft Covenant
Holcroft CovenantHolcroft Covenant
- Robert Ludlum
- anglické
- 560
- 2010
The most dangerous legacy...A superb thriller from ''a writer who bests the bestsellers'' Daily TelegraphThe Second World War is over. Three top Nazis have embezzled $780...
 Bourne fölénye
Bourne fölényeBourne fölénye
- Robert Ludlum
- I.P.C. Könyvek
Jason Bourne lehetetlen feladattal találja szemben magát ebben a bravúros regényben. Megbízzák, hogy személyesítsen meg egy minisztert egy Katarban tartott politikai...
 Hazafias játszma
Hazafias játszmaHazafias játszma
- Robert Ludlum
- I.P.C. Könyvek
Az anyatermészet sosem hagyná, hogy egy olyan csekély hatalom, mint az emberi elme, átvegye felette az irányítást. A Covert-One ügynökét, Jon Smith ezredest Japánba küldik,...
 Gemini Contenders
Gemini ContendersGemini Contenders
- Robert Ludlum
- anglické
- 504
- 2010
- Orion
December 1939. A train winds its way through Italy towards the Alps with a cargo too precious to destroy, too awful to reveal. On board is an iron box. Its sinister contents,...
 Robert Ludlum's The Altman Code Ludlum Robert
Robert Ludlum's The Altman Code Ludlum RobertRobert Ludlum's The Altman Code Ludlum Robert
- Robert Ludlum
- anglické
- 490
- 2010
- Orion
The fourth instalment in the COVERT-ONE series from the master of the thriller genre. On the dark waterside docks of Shanghai, a photographer records cargo being secretly...
 The Scarlatti Inheritance
The Scarlatti InheritanceThe Scarlatti Inheritance
- Robert Ludlum
- anglické
- 400
- 2021
- Orion
Jazyk: Angličtina, Väzba: Brožovaná, Počet strán: 400, Nakladateľstvo: Orion Publishing Co, Autor: Robert Ludlum, ISBN-13: 9781398705715, Dátum vydania: 2021
 Janson Directive Ludlum Robert
Janson Directive Ludlum RobertJanson Directive Ludlum Robert
- Robert Ludlum
- anglické
- 625
- 2010
- Robert Ludlum
The Sunday Times bestselling thriller from ''the world''s most read writer'' GQ''A writer who bests the bestsellers'' Daily TelegraphRetired operative Paul Janson is called...
 Bourne Ultimatum Book and MP3 Pack -
Bourne Ultimatum Book and MP3 Pack -Bourne Ultimatum Book and MP3 Pack -
- Robert Ludlum
- anglické
- 113
- 2012
- Pearson Education Limited
At a small-town carnival, two men, each mysteriously summoned by telegram, witness a bizarre killing. The telegrams are signed "Jason Bourne." Only they know Bourne's true...
 The Osterman Weekend - Robert Ludlum
The Osterman Weekend - Robert LudlumThe Osterman Weekend - Robert Ludlum
- Robert Ludlum
- anglické
- 250
- 2009
- Robert Ludlum
In a secret room in Washington DC John Tanner is asked to stake his life and those of his wife and children on a gamble whose goals and risks no one will fully reveal to him....
 The Cassandra Compact - Robert Ludlum
The Cassandra Compact - Robert LudlumThe Cassandra Compact - Robert Ludlum
- Robert Ludlum
- anglické
- 396
- 2009
- Ludlum
What they're going to do, I would never have believed it. It's insanity! They were the last words spoken by Yuri Danko, an officer in the medical division of Russia's security...
The Hades Factor - Robert Ludlum
The Hades Factor - Robert LudlumThe Hades Factor - Robert Ludlum
- Robert Ludlum
- anglické
- 432
- 2009
- Robert Ludlum
A homeless man in Boston, an Army Major in California, and a teenage girl in Atlanta all die suddenly and painfully - each a victim of an unknown doomsday virus. For three...
 Robert Ludlum's The Utopia Experiment - Robert Ludlum
Robert Ludlum's The Utopia Experiment - Robert LudlumRobert Ludlum's The Utopia Experiment - Robert Ludlum
- Robert Ludlum
- anglické
- 448
- Robert Ludlum
ISBN: 9781409102441 Robert Ludlum Orion 27.2.2014 The Merge: a device destined to revolutionise the world and make the personal computer and smart phone obsolete. When...
